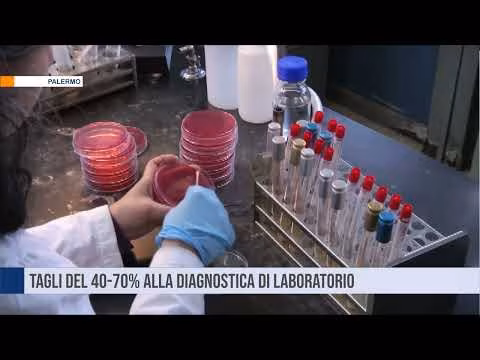
Tagli del 40/70% per la diagnostica di laboratorio

Tagli del 40/70% per la diagnostica di laboratorio. La protesta dei laboratori di analisi

https://www.youtube.com/watch?v=UNcUhOrvHAQ
Sciopero dei laboratori di analisi e centri diagnosi siciliani. Il motivo, il nuovo tariffario che prevede tagli del 40-70% per la diagnostica di laboratorio. TELE ONE canale 16 in tutta la Sicilia, in diretta streaming su www.teleone.it, https://www.facebook.com/teleone.it e sull'App teleOne. All rights reserved – Questo video è protetto da copyright ed è espressamente vietato ogni utilizzo, riproduzione od uso, parziale o totale